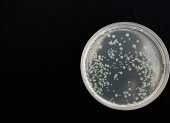
Un nuevo estudio científico halló novedades preocupantes sobre el comportamiento del coronavirus o COVID-19. Foto referencial.

Lola Índigo está indignada con la prensa española
Paulina Dávila
La artista madrileña se quejó por Twitter del tratamiento que había recibido una entrevista que concedió a la revista Glamour.

Paulina Dávila
La artista madrileña se quejó por Twitter del tratamiento que había recibido una entrevista que concedió a la revista Glamour.

Martha Torres
Las universidades dictan sus clases y ofrecen trámites administrativos a través de sus plataformas. Otras actividades educativas están postergadas
José López
La cuarentena tiene algunos efectos psicológicos sobre los deportistas de alto rendimiento. Hay consejos para soportarla
Herbert Holguín
Un reciente estudio científico sobre el nuevo coronavirus o COVID-19 descubre nuevas características del causante de la actual pandemia.
Javier Montenegro
Las muestras para detectar el Covid-19 se toman en el domicilio. Hay tarifas establecidas

Gilson Pinargote
La aerolínea pretende llevar a los turistas extranjeros hacía el continente para que puedan tomar sus conexiones internacionales hacia sus países de origen.

Estefanía Ortiz
Según la concesionaria, el 18 de marzo uno de sus empleados fue apresado por problemas con su salvoconducto.

Alfonso Albán
En la provincia del Guayas seguirá empezando a las 16:00 como ya fuero resuelto por el COE Nacional

Gilson Pinargote
Rompió récords de audiencia con un final dudoso. Se rumora que habrá nuevos personajes para lo que viene.

Cristina Bazán
El Ministerio Público solicitó a TAGSA los vídeos de las cámaras de seguridad instaladas en la terminal aérea





Más visto